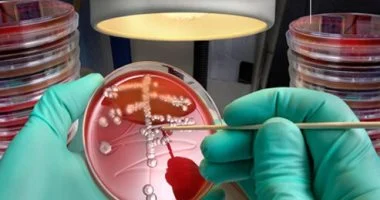

سيكولوجية التوازن والتكامل: كيف تحققين السيادة المهنية والسعادة الشخصية دون السقوط في فخ الاحتراق؟ إن المفهوم الحديث للتوازن بين الحياة والعمل لا يعني تقسيم اليوم بالمسطرة بين المكتب والمنزل، بل […]
جودة الحياة
السر الياباني لحياة مديدة، سعيدة، وذات معنى
14 يناير, 2026, غير مصنف, No Commentفلسفة “الإيكيجاي”: السر الياباني لحياة مديدة، سعيدة، وذات معنى! لماذا يعيش سكان جزيرة “أوكيناوا” في اليابان لأكثر من مئة عام بصحة جيدة وسعادة غامرة؟ البحث عن “سر التعمير” و”كيف أجد […]
الدراسة الصادمة لعام 2026 حول انقطاع النفس النومي والاكتئاب
3 يناير, 2026, صحة, No Commentلماذا يستيقظ عقلك متعباً؟ الدراسة الصادمة لعام 2026 حول انقطاع النفس النومي والاكتئاب لطالما تعاملنا مع “انقطاع النفس النومي” (Sleep Apnea) على أنه مشكلة جسدية بحتة، مرتبطة بزيادة الوزن أو […]
لقاح HPV للرجال.. حماية تتجاوز الوقاية من العدوى
26 ديسمبر, 2025, صحة, No Commentلقاح HPV للرجال.. حماية تتجاوز الوقاية من العدوى في عام 2026، يبرز لقاح فيروس الورم الحليمي كواحد من أنجح الابتكارات في “الطب الوقائي” للرجال. لا تقتصر فوائد اللقاح على منع […]
الأثر المدمر لـ “طُعم الغضب” على صحتك النفسية وكيفية النجاة
26 ديسمبر, 2025, صحة, No Commentالأثر المدمر لـ “طُعم الغضب” على صحتك النفسية وكيفية النجاة خلف الشاشات، يترك “طُعم الغضب” آثاراً كيميائية ونفسية عميقة ومدمرة. عندما تقع في فخ محتوى مستفز، يقوم دماغك بإفراز كميات […]
روشتة السعادة النفسية في 2026.. 7 خطوات لاستعادة توازنك
26 ديسمبر, 2025, صحة, No Commentروشتة السعادة النفسية في 2026.. 7 خطوات لاستعادة توازنك تعتمد استراتيجية الصحة النفسية لعام 2026 على مفهوم “المرونة النفسية الرقمية”. أولى خطوات هذه الروشتة هي “الصيام الرقمي المجدول”؛ حيث ينصح […]
12 خطوة بسيطة تضمن لكِ حياة مديدة وصحية مع السكري
26 ديسمبر, 2025, صحة, No Comment12 خطوة بسيطة تضمن لكِ حياة مديدة وصحية مع السكري في عالم الطب لعام 2026، أصبح التركيز ينصب على “جودة الحياة” لمريض السكري. الخطوات الـ 12 التي نوصي بها ليست […]
مستقبل علاج ثنائي القطب.. هل تكمن الحلول في تعديل ميكروبيوم الأمعاء
25 ديسمبر, 2025, صحة, No Commentمستقبل علاج ثنائي القطب.. هل تكمن الحلول في تعديل ميكروبيوم الأمعاء؟ لطالما كان اضطراب ثنائي القطب لغزاً يحاول العلماء فك شفراته عبر دراسة الجينات وكيمياء الدماغ، ولكن التطور العلمي في […]
كيف يحمي علاج الاكتئاب دماغك من التدهور المعرفي؟ رؤية من لانسيت
22 ديسمبر, 2025, صحة, No Commentكيف يحمي علاج الاكتئاب دماغك من التدهور المعرفي؟ رؤية من لانسيت أحدثت الدراسة المنشورة في مجلة لانسيت الطبية ثورة في فهم العلاقة بين المشاعر والقدرات الذهنية، حيث أثبتت أن علاج […]
محور “الأمعاء-الدماغ”.. كيف تؤثر جودة الكربوهيدرات على ذكائك
18 ديسمبر, 2025, صحة, No Commentمحور “الأمعاء-الدماغ”.. كيف تؤثر جودة الكربوهيدرات على ذكائك؟ يكمن التفسير العلمي الأعمق للدراسة التي تربط بين جودة الكربوهيدرات والوقاية من الخرف في منطقة قد لا نتوقعها: الأمعاء. في عام 2025، […]